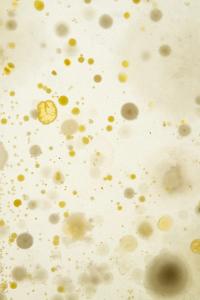
Untitled | DER GREIF

Subscribe to the Newsletter

Pupa, a stage of a metamorphic insect’s life (such as a butterfly, a moth, or a bee), occurs between the larva and the imago. It is when an insect is enclosed in a cocoon or a protective covering and undergoes internal changes - in other words, a transformation - to reach a new stage. This project aims to treat photography as if it were in a pupa: in a stage of transition, temporality, and transformation.
As photography is traditionally an extremely controlled, fixed, and human-oriented process, it reflects on hierarchy within image-making. By investigating conditions in which organisms such as bacteria, fungi, and plants live, I aim to actively involve the non-human other in the photographic process in order to question the image as well as my own control as an image maker. The process acts as a symbol for re-understanding our environment, from an anthropocentric to an ecocentric perspective.
Bacteria and fungi are invited to find home on large film negatives and continuously alter the image. The images portray landscapes of the Netherlands, environments that are thoroughly controlled by humans. By growing various bacteria and fungi on the film negatives, control is given back to organic processes, and the image is repurposed to become a place to live. At the same time, conventional knowledge of looking is challenged when fungi start growing out of seminal books about photography, creating organic sculptures that provide fruits for alternative ways of knowing.
It all comes together in one temporary, transformative matter that never looks or acts the same, where stillness and control are challenged.
Ieva Maslinskaitė is part of »Guest Room: Michael Famighetti«.